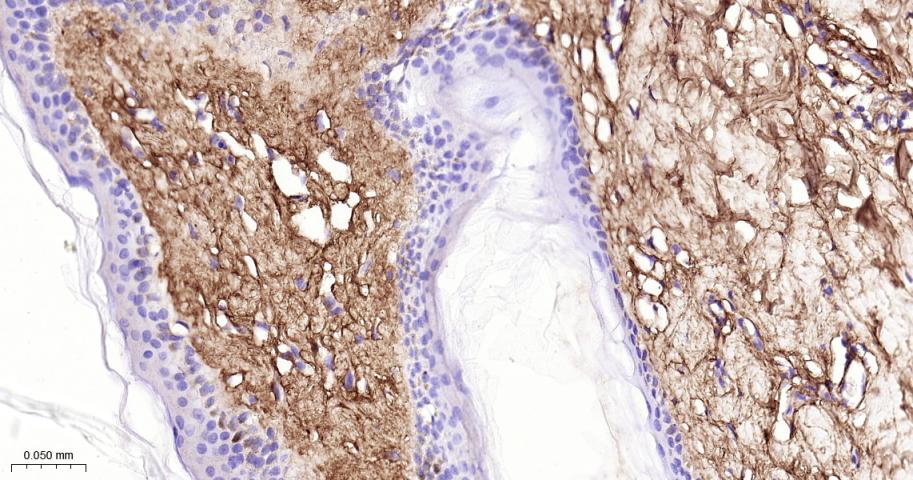
III型胶原单克隆抗体-bsm-33129M
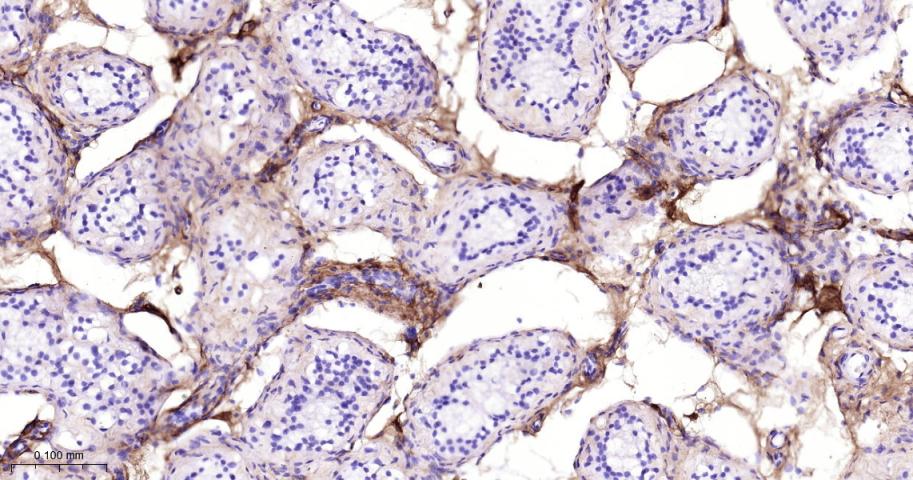
III型胶原单克隆抗体-bsm-33129M
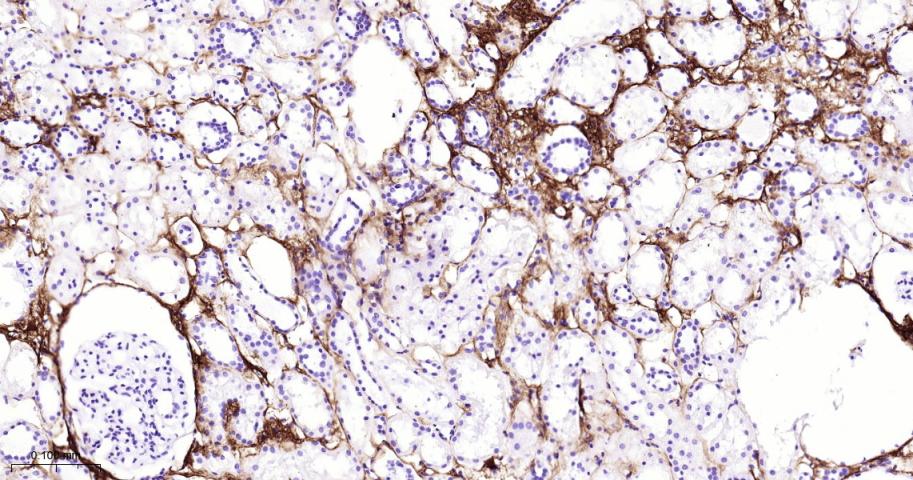
III型胶原单克隆抗体-bsm-33129M

Collagen III Mouse mAb (一抗) - WB,IHC-P,IHC-F,IF,ICC/IF | Bioss

货号:bsm-33129M
产品详情
相关标记
相关产品
相关文献
常见问题
概述
产品编号
bsm-33129M
产品类型
mIHC精品抗体
英文名称
Collagen III Mouse mAb
中文名称
III型胶原单克隆抗体
英文别名
EDS4A; EDSVASC; PMGEDSV; Col3a-1; Tsk-2; Tsk2; CO3A1_BOVIN; COL3A1; CO3A1_HUMAN; CO3A1_MOUSE; CO3A1_RAT; collagen type III alpha 1 chain; Ehlers-Danlos syndrome type IV, autosomal dominant; collagen, type III, alpha 1
抗体来源
Mouse
免疫原
Recombinant human Collagen III protein
亚型
IgG
性状
Size : 50ul/100ul/200ul
Liquid
Size : 200ug (PBS only)
Lyophilized
Note: Centrifuge tubes before opening. Reconstitute the lyophilized product in distilled water. Optimal concentration should be determined by the end user.
Liquid
Size : 200ug (PBS only)
Lyophilized
Note: Centrifuge tubes before opening. Reconstitute the lyophilized product in distilled water. Optimal concentration should be determined by the end user.
纯化方法
affinity purified by Protein G
克隆类型
Monoclonal
克隆号
7B6
理论分子量
117 kDa
检测分子量
150-200 kDa
浓度
1mg/ml
储存液
Size : 50ul/100ul/200ul
0.01M TBS (pH7.4) with 1% BSA, 0.02% Proclin300 and 50% Glycerol.
Size : 200ug (PBS only)
0.01M PBS
0.01M TBS (pH7.4) with 1% BSA, 0.02% Proclin300 and 50% Glycerol.
Size : 200ug (PBS only)
0.01M PBS
研究领域
SWISS
Gene ID
保存条件
Shipped at 4℃. Store at -20℃ for one year. Avoid repeated freeze/thaw cycles.
注意事项
This product as supplied is intended for research use only, not for use in human, therapeutic or diagnostic applications.
数据库链接
背景资料
The extensive family of COL gene products (collagens) is composed of several chain types, including fibril-forming interstitial collagens (types I, II, III and V) and basement membrane collagens (type IV), each type containing multiple isoforms. Collagens are fibrous, extracellular matrix proteins with high tensile strength and are the major components of connective tissue, such as tendons and cartilage. All collagens contain a triple helix domain and frequently show lateral self-association in order to form complex connective tissues. Several collagens also play a role in cell adhesion, important for maintaining normal tissue architecture and function.
This gene encodes the pro-alpha1 chains of type III collagen, a fibrillar collagen that is found in extensible connective tissues such as skin, lung, uterus, intestine and the vascular system, frequently in association with type I collagen. Mutations in this gene are associated with Ehlers-Danlos syndrome types IV, and with aortic and arterial aneurysms. Two transcripts, resulting from the use of alternate polyadenylation signals, have been identified for this gene.
This gene encodes the pro-alpha1 chains of type III collagen, a fibrillar collagen that is found in extensible connective tissues such as skin, lung, uterus, intestine and the vascular system, frequently in association with type I collagen. Mutations in this gene are associated with Ehlers-Danlos syndrome types IV, and with aortic and arterial aneurysms. Two transcripts, resulting from the use of alternate polyadenylation signals, have been identified for this gene.

产品应用
| 应用 | 已检合格种属 | 预测种属 | 推荐稀释比例 |
|---|---|---|---|
| WB | Human | 1:500-2000 | |
| IHC-P | Human | 1:500-1000 | |
| IHC-F | Human | 1:500-1000 | |
| IF | Human | 1:500-1000 | |
| ICC/IF | Human | 1:100-200 |
交叉反应
交叉反应: Human
相关产品
暂无相关产品
靶标
基因名
COL3A1
蛋白名
Collagen alpha-1(III) chain
亚基
Trimers of identical alpha 1(III) chains. The chains are linked to each other by interchain disulfide bonds. Trimers are also cross-linked via hydroxylysines.
亚细胞定位
Secreted, extracellular space, extracellular matrix.
翻译后修饰
Proline residues at the third position of the tripeptide repeating unit (G-X-Y) are hydroxylated in some or all of the chains.
O-linked glycan consists of a Glc-Gal disaccharide bound to the oxygen atom of a post-translationally added hydroxyl group.
O-linked glycan consists of a Glc-Gal disaccharide bound to the oxygen atom of a post-translationally added hydroxyl group.
疾病
Defects in COL3A1 are a cause of Ehlers-Danlos syndrome type 3 (EDS3) [MIM:130020]; also known as benign hypermobility syndrome. EDS is a connective tissue disorder characterized by hyperextensible skin, atrophic cutaneous scars due to tissue fragility and joint hyperlaxity. EDS3 is a form of Ehlers-Danlos syndrome characterized by marked joint hyperextensibility without skeletal deformity.
Defects in COL3A1 are the cause of Ehlers-Danlos syndrome type 4 (EDS4) [MIM:130050]. EDS is a connective tissue disorder characterized by hyperextensible skin, atrophic cutaneous scars due to tissue fragility and joint hyperlaxity. EDS4 is the most severe form of the disease. It is characterized by the joint and dermal manifestations as in other forms of the syndrome, characteristic facial features (acrogeria) in most patients, and by proneness to spontaneous rupture of bowel and large arteries. The vascular complications may affect all anatomical areas.
Defects in COL3A1 are a cause of susceptibility to aortic aneurysm abdominal (AAA) [MIM:100070]. AAA is a common multifactorial disorder characterized by permanent dilation of the abdominal aorta, usually due to degenerative changes in the aortic wall. Histologically, AAA is characterized by signs of chronic inflammation, destructive remodeling of the extracellular matrix, and depletion of vascular smooth muscle cells.
Defects in COL3A1 are the cause of Ehlers-Danlos syndrome type 4 (EDS4) [MIM:130050]. EDS is a connective tissue disorder characterized by hyperextensible skin, atrophic cutaneous scars due to tissue fragility and joint hyperlaxity. EDS4 is the most severe form of the disease. It is characterized by the joint and dermal manifestations as in other forms of the syndrome, characteristic facial features (acrogeria) in most patients, and by proneness to spontaneous rupture of bowel and large arteries. The vascular complications may affect all anatomical areas.
Defects in COL3A1 are a cause of susceptibility to aortic aneurysm abdominal (AAA) [MIM:100070]. AAA is a common multifactorial disorder characterized by permanent dilation of the abdominal aorta, usually due to degenerative changes in the aortic wall. Histologically, AAA is characterized by signs of chronic inflammation, destructive remodeling of the extracellular matrix, and depletion of vascular smooth muscle cells.
相似性
Belongs to the fibrillar collagen family.
Contains 1 fibrillar collagen NC1 domain.
Contains 1 VWFC domain.
Contains 1 fibrillar collagen NC1 domain.
Contains 1 VWFC domain.
功能
Collagen type III occurs in most soft connective tissues along with type I collagen.
同靶标产品
相关文献
提示: 发表研究结果有使用 bsm-33129M 时请让我们知道,以便我们可以引用参考文章。作为回馈,资料提供者将获得我们送上的小礼品。
具体参考文献:bsm-33129M 被引用于4文献中